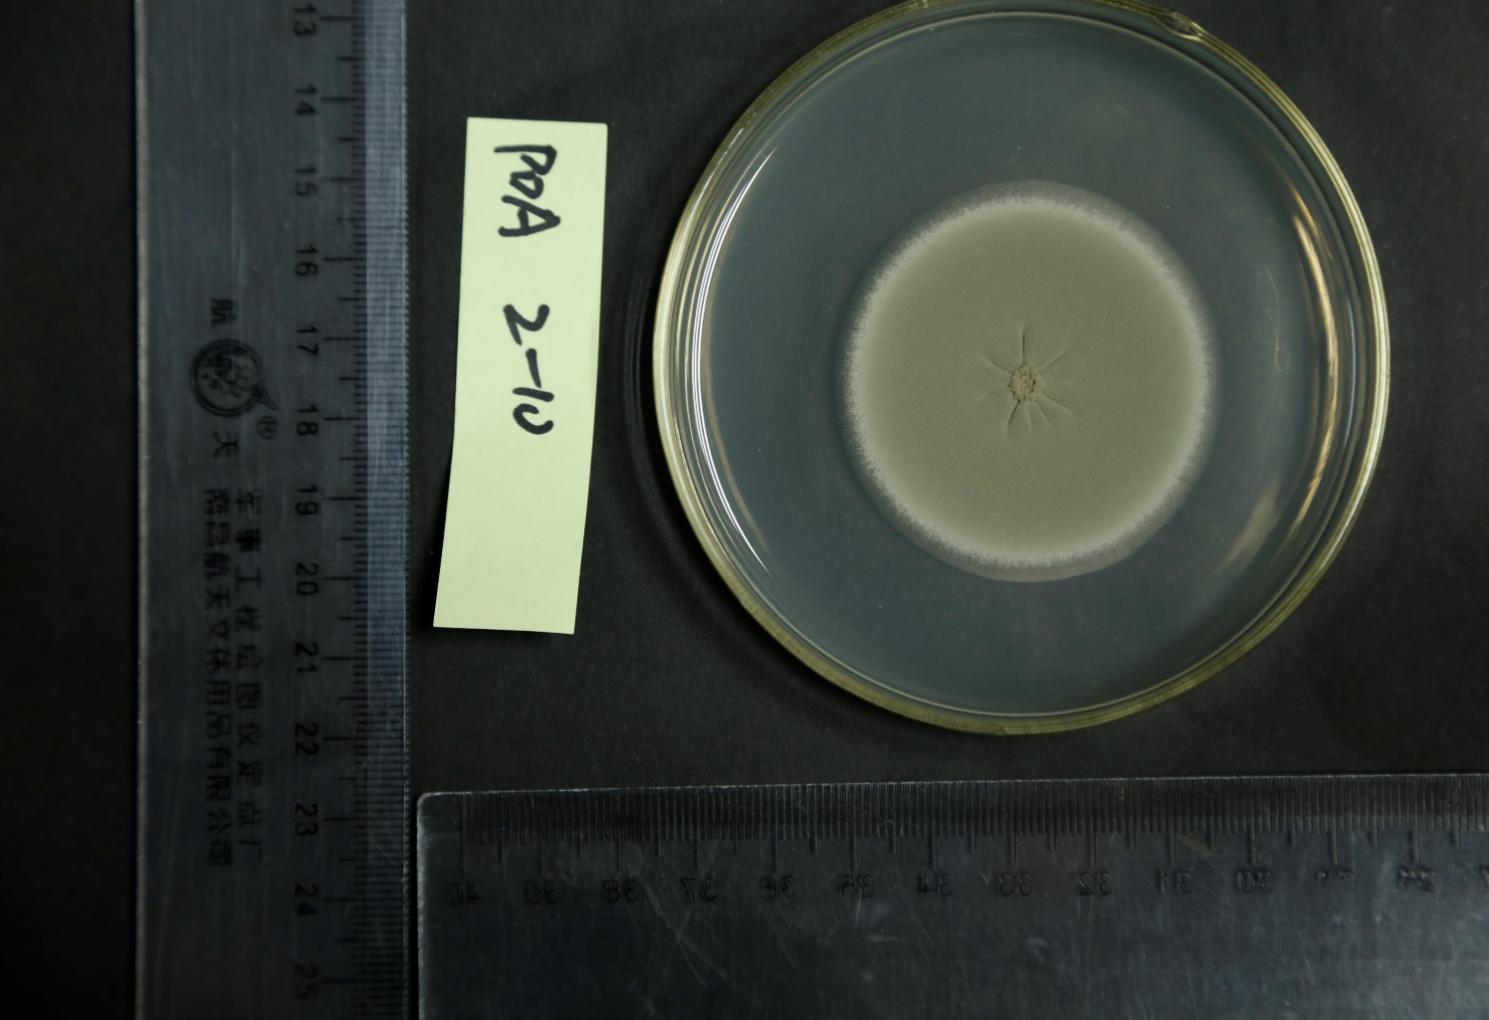

成果简介
围绕无蒸煮淀粉生料发酵生物技术创新,利用组学技术解析丝状真菌生淀粉酶基因的表达调控网络、生淀粉酶基因调控元件等;通过随机诱变育种、理性分子设计和遗传改造技术,获得了一系列高产生淀粉酶的基因工程/突变菌株,包括OPoxGA15A、A2-13、TE4-10、GXU001、GXU002和W2-10,在以木薯生淀粉为底物时,最高生淀粉酶产量达到500 U/mL,是目前文献报道最高的。该生淀粉酶对生小麦淀粉、生玉米淀粉、生水稻淀粉和生木薯淀粉的水解率均近100%。单独草酸青霉突变株产生淀粉酶或与商业α-淀粉酶协同进行木薯淀粉无蒸煮生料发酵生产燃料乙醇,发酵醪酒分> 15% (v/v)、酒精发酵率> 95%。目前,在广西中粮生物质能源有限公司进行木薯淀粉生料同步糖化发酵产酒精小试结果很好,达到预期。
应用前景
本成果在燃料乙醇行业有很大的应用前景。应用本产品进行生料发酵,每生产1吨酒精将比现在熟料发酵工艺节省近200元。如按照年产20万吨燃料乙醇计算,每年生料发酵比熟料发酵节约成本3674万元,利税918万元。另外,本成果在饲料行业、淀粉糖行业等也有较大的应用潜力。在传统糖化酶市场,作为新产品,能占有部分市场,有很大的市场销售潜力。
成熟度
小试。
成果展示
图1 草酸青霉突变株W2-10

图2 草酸青霉液体生淀粉酶制剂
知识产权情况
序号 |
专利号 |
成果名称 |
1 |
CN202211268625.7 |
草酸青霉基因工程菌GXUR001及其在制备生淀粉酶制剂中应用 |
2 |
ZL202011170084.5 |
草酸青霉突变株A2-13及其在制备生淀粉酶制剂与降解生淀粉中的应用 |
3 |
ZL201810816723.7 |
一种高产生木薯淀粉酶的草酸青霉工程菌及其应用 |
| 4 |
ZL201010272065.3 |
产生生淀粉酶的青霉菌及其制备的生淀粉酶制剂 |
成果完成人
生命科学与技术学院:冯家勋,赵帅
成果转化,请联系成果与合作处,联系人:王老师,联系电话:0771-3810467。